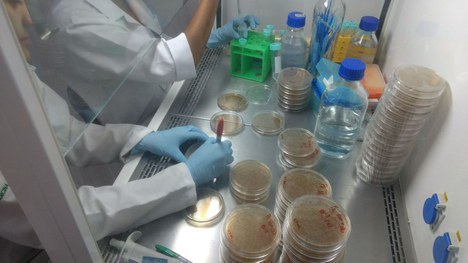

Notícias
DIA MUNDIAL DA ÁGUA
Projetos apoiados pelo Programa Entre Mares são destaque

Nesta segunda-feira, 22 de março, é comemorado o Dia Mundial da Água. A data, instituída em 1992 pela Organização das Nações Unidas (ONU), tem como objetivo a conscientização da população mundial sobre a importância do tema. Atenta aos danos ambientais e socioeconômicos provocados por desastres neste meio, a CAPES criou o Programa Entre Mares .
A iniciativa pretende reduzir os danos causados pelo derramamento de óleo no litoral brasileiro, em 2019. Um dos projetos selecionados investiga a ação de microrganismo na biodegradação do petróleo no oceano. O estudo multidisciplinar envolve as áreas de Oceanografia, Biologia e Microbiologia das Universidades Federais do Rio de Janeiro (UFRJ), Brasília (UnB) e Alagoas (Ufal) e da Estadual de Santa Cruz (Uesc), na Bahia. Ele sugere que microrganismos marinhos que se alimentam do contaminante produzem uma espécie de detergente natural, chamado biossurfactante, que ajuda a dissolver o óleo na água.
Fabiano Thompson, coordenador do projeto e professor de Biologia do Programa de Engenharia de Produção do Instituto Alberto Luiz Coimbra de Pós-Graduação e Pesquisa (UFRJ), avalia os impactos ambientais e socioeconômicos, a remediação biológica – técnica que usa agentes biológicos degradadores para despoluir as áreas contaminadas –, a dispersão do óleo, o processamento de resíduos e a tecnologia aplicada à contenção do petróleo. Segundo Fabiano, o estudo permite entender melhor o processo de biodegradação do petróleo no oceano e a toxicidade do produto no mar.
Outro projeto, desta vez do Instituto de Computação da Universidade Federal de Alagoas (Ufal), propõe o uso de drones para monitorar o litoral brasileiro. Segundo o estudo, veículos aéreos e aquáticos, seriam capazes de identificar possíveis danos ambientais. Equipamentos aéreos e marítimos autônomos podem vir, em breve, a vigiar as águas do litoral brasileiro para sinalizar eventuais derramamentos de óleo ou outros tipos de poluentes químicos.

“O grande problema destes sistemas é que eles são estáticos, mas os oceanos não. Acreditamos que veículos aéreos e marítimos seriam capazes de monitorar eventos que acontecem na costa brasileira e que estão suscetíveis à dinâmica dos mares por causa das correntes marítimas, da mudança dos ventos, das alterações climáticas e de todo tipo de fenômeno meteorológico fora da normalidade”, explica Heitor Savino, cientista do Instituto de Computação da Ufal, que lidera o grupo de pesquisa.
Atualmente, a costa brasileira é monitorada por estações maregráficas que mantém 189 boias em todo o País. Outras 21 boias fixas são oferecidas pelo programa Prediction and Research Moored Array in the Tropical Atlantic (em livre tradução: Predição e Pesquisa em Matriz Atracada no Atlântico Tropical), o Pirata. Com o desenvolvimento de drones, pesquisadores acreditam que o Brasil poderia ter capacidade de vigiar uma faixa marítima que se estende até 24 milhas náuticas (aproximadamente 44 km), compreendendo o mar territorial e a zona contígua.
Programa Entre Mares
Em 2019, as praias do Nordeste receberam manchas de óleo que deixaram um rastro de poluição. O Programa Entre Mares é uma iniciativa da CAPES diante do desastre ambiental gerado no litoral brasileiro. O Edital, de R$ 1.360.000,00 (um milhão, trezentos e sessenta mil reais), selecionou 12 projetos de pós-graduação que apresentam soluções de combate e análise do impacto do derramamento de óleo.
Legenda das imagens:
Imagem 1: O projeto é coordenado por Fabiano Thompson, professor de Biologia da Universidade Federal do Rio de Janeiro (UFRJ) (Foto: Arquivo pessoal)
Imagem 2: Amostras do mar poluído com petróleo (Foto: Arquivo pessoal)
Imagem 3: Heitor Savino, cientista do Instituto de Computação da Ufal, que lidera o grupo de pesquisa (Foto: Arquivo pessoal)
A Coordenação de Aperfeiçoamento de Pessoal de Nível Superior (CAPES) é um órgão vinculado ao Ministério da Educação (MEC).
(Brasília – Redação CCS/CAPES)
A reprodução das notícias é autorizada desde que contenha a assinatura CCS/CAPES